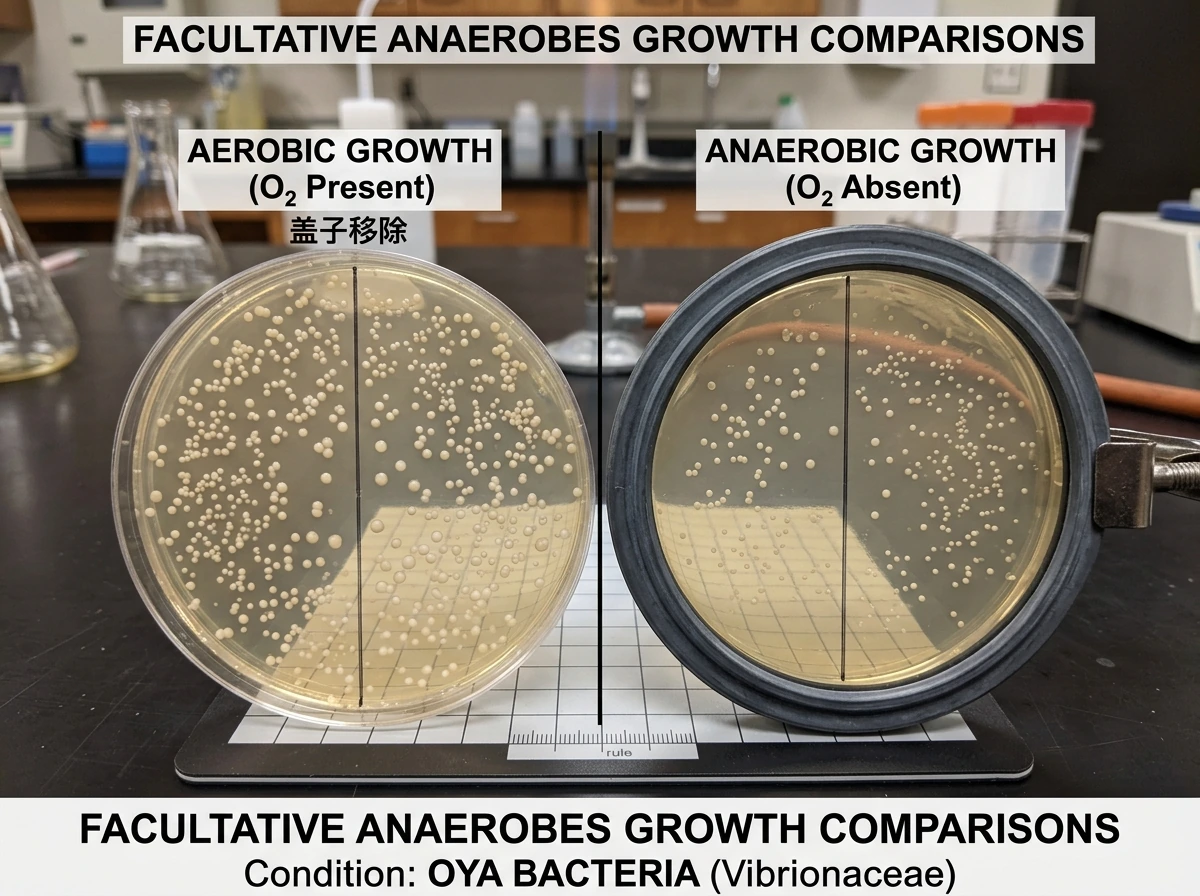
Facultative anaerobe growth shown in both oxygen-present and oxygen-absent conditions

Organisms that can grow with or without oxygen present are called facultative anaerobes. That is the direct answer, and it is the term you need to know cold if you are studying microbiology. But the full picture is a little richer than one label, because there are actually five distinct oxygen-requirement categories, and mixing them up is one of the most common mistakes students make on exams and in the lab. This guide will walk you through each category, show you exactly how to tell them apart from wording alone, and explain why any of this matters outside a textbook.
Organisms That Can Grow With or Without Oxygen
Oxygen-based classification basics

Microbiologists classify bacteria and other microbes by their relationship to oxygen because oxygen is not just a growth factor, it is a metabolic tool and, for some organisms, a deadly poison. Depending on whether an organism can use oxygen for respiration, merely tolerate it, require it, or must avoid it entirely, it falls into one of five core categories. Each category reflects something real about how that organism generates energy and manages the toxic byproducts of oxygen chemistry.
Oxygen, when it reacts inside a cell, produces reactive oxygen species like superoxide anions and hydrogen peroxide. These are genuinely damaging to cellular machinery. Organisms that thrive in oxygen typically carry enzymes like superoxide dismutase (SOD), catalase, and peroxidase to neutralize these byproducts. Organisms that lack those enzymes are often killed or harmed by oxygen exposure. That biological reality is what drives the entire classification system.
| Category | Grows with O2? | Grows without O2? | Uses O2 for respiration? | Notes |
|---|---|---|---|---|
| Obligate aerobe | Yes (required) | No | Yes | Dies or fails to grow without O2 |
| Obligate anaerobe | No (toxic or inhibitory) | Yes (required) | No | Cannot perform aerobic metabolism; damaged by O2 |
| Facultative anaerobe | Yes (preferred) | Yes | Yes when available | Grows better with O2 but survives without it |
| Aerotolerant anaerobe | Yes (tolerated) | Yes | No | Never uses O2 for respiration; just is not harmed by it |
| Microaerophile | Yes (low levels only) | No (or very poorly) | Yes, at low concentrations | Requires 2–10% O2; harmed by full atmospheric levels (21%) |
Correct term for bacteria that grow without oxygen
Bacteria that grow without oxygen are called anaerobes, but that label covers two very different situations, and it is important not to lump them together.
Obligate anaerobes (also called strict anaerobes) can only grow in the complete absence of oxygen. Oxygen is not just unnecessary for them, it is actively harmful. Clostridium perfringens, the bacterium behind some serious food poisoning cases, is a classic example. Organisms that may even grow in certain chemical disinfectants is Expose a strict anaerobe to atmospheric oxygen and it struggles to survive.
Aerotolerant anaerobes are a different story. They also never use oxygen for respiration, meaning they are metabolically anaerobic, but they can tolerate oxygen exposure without being killed by it. Many Lactobacillus species fall into this group. They ferment sugars the same way whether oxygen is present or not, and oxygen in the environment does not stop them from growing. This is a common misconception worth flagging: aerotolerant does not mean oxygen-loving or oxygen-using. It just means oxygen-tolerant. Most aerotolerant anaerobes test negative for catalase, which is one useful lab clue for distinguishing them from facultative anaerobes.
Correct term for bacteria that grow with or without oxygen
The correct term for organisms that can grow either with oxygen or without it is facultative anaerobe. When a question uses the phrasing 'can grow with or without oxygen,' that wording is describing a facultative anaerobe, full stop.
Facultative anaerobes are flexible because they can actually switch their metabolic strategy. When oxygen is available, they use aerobic respiration, which is more energy-efficient. When oxygen is absent, they shift to fermentation or anaerobic respiration. Staphylococcus aureus, commonly found on skin and associated with food contamination, is a well-known facultative anaerobe. Many familiar gut bacteria, including Escherichia coli, are also facultative anaerobes. This flexibility is a real survival advantage: it lets them thrive in environments where oxygen levels fluctuate.
Here is where students sometimes stumble: aerotolerant anaerobes also grow with or without oxygen, so why are they not the answer? The distinction is metabolic. Aerotolerant organisms cannot use oxygen for respiration at all. Facultative anaerobes can and do use oxygen when it is there. If the question specifies that the organism actively uses or prefers oxygen but can also manage without it, that is facultative. If the question says the organism ignores oxygen entirely (neither uses nor is harmed by it), that is aerotolerant.
What these categories mean for growth and metabolism
The classification is not just a vocabulary exercise. It reflects something mechanistically real about how each type of organism produces energy and protects itself from chemical damage.
Obligate aerobes depend on aerobic respiration entirely. Oxygen serves as their terminal electron acceptor in the electron transport chain, which is how they extract the most energy from nutrients. Remove oxygen and they cannot generate energy efficiently, so they stop growing or die. Microaerophiles are similar but have adapted to work with reduced oxygen levels, typically between 2 and 10 percent, rather than the 21 percent found in normal air. They still use oxygen as a metabolic ingredient, but too much of it causes oxidative damage they cannot fully handle.
Facultative anaerobes carry the full enzymatic toolkit, including superoxide dismutase and catalase, to manage reactive oxygen species. That is why they can operate aerobically without being damaged. When they switch to anaerobic conditions, they rely on fermentation or anaerobic respiration, which yields less energy per unit of nutrient but keeps the organism viable. This is why facultative anaerobes tend to grow more densely in an oxygen-rich environment but will still grow (just less vigorously) without it.
Aerotolerant anaerobes use fermentation exclusively regardless of whether oxygen is around. They carry enough protective capacity (though not necessarily catalase) to avoid being destroyed by oxygen, but they gain nothing metabolically from it. Their growth rate looks roughly the same in aerobic and anaerobic conditions because their energy source does not change.
How to identify the right label from a question

The wording of the question is your biggest clue. Here is a practical decision framework you can use on any exam or quiz.
- Does the organism REQUIRE oxygen and die without it? That is an obligate aerobe.
- Does the organism REQUIRE oxygen but only at low levels (2–10%) and grow poorly without it? That is a microaerophile.
- Does the organism GROW with or without oxygen and PREFER oxygen (grows better with it, actively uses it for respiration)? That is a facultative anaerobe.
- Does the organism GROW with or without oxygen but NEVER use oxygen for respiration (same growth in both conditions)? That is an aerotolerant anaerobe.
- Does the organism grow ONLY without oxygen and is harmed or killed by oxygen exposure? That is an obligate (strict) anaerobe.
Pay close attention to verbs. 'Requires' points to aerobes or microaerophiles. 'Tolerates but does not use' points to aerotolerant anaerobes. 'Can use when available, but also survives without' is the classic facultative anaerobe description. 'Cannot survive in the presence of' is an obligate anaerobe. A question that says 'grows with or without oxygen' without specifying oxygen use most likely describes a facultative anaerobe in a standard microbiology course context, but if the question adds 'does not use oxygen for respiration,' it is pointing you toward aerotolerant.
In the lab, thioglycollate broth is the standard tool for making this determination visually. Sodium thioglycolate consumes oxygen and creates a gradient from aerobic conditions near the top to fully anaerobic conditions at the bottom. Here is what growth patterns tell you:
- Growth only at the top: obligate aerobe
- Growth only at the bottom: obligate anaerobe
- Growth throughout the tube but denser near the top: facultative anaerobe
- Growth evenly distributed throughout: aerotolerant anaerobe
- Growth in a band just below the surface (not at the very top): microaerophile
A catalase test adds another layer. Facultative anaerobes typically test positive for catalase, while most aerotolerant anaerobes test negative. Streptococci (aerotolerant) are catalase-negative; staphylococci (facultative anaerobes) are catalase-positive. That single enzyme test can help you separate the two groups that both grow in the presence and absence of oxygen.
Real-world implications: food safety, lab culture, and hygiene
Understanding oxygen requirements is not just a classroom exercise. It directly predicts where specific bacteria will grow and what conditions make them dangerous.
Food safety
Clostridium botulinum and Clostridium perfringens are obligate anaerobes. C. botulinum produces the toxin responsible for botulism in improperly sealed canned or vacuum-packed foods, precisely because those environments exclude oxygen. C. perfringens type A causes food poisoning when cooked meat is held at unsafe temperatures in large batches where interior zones become oxygen-depleted. Knowing these organisms are strict anaerobes tells you that sealing a food container tightly, rather than leaving it open, can actually increase the risk for this particular hazard.
Facultative anaerobes like E. coli and Staphylococcus aureus are a different concern. Because they grow in both aerobic and anaerobic conditions, they can contaminate food surfaces exposed to air and then continue growing once food is packaged or stored. Refrigeration slows their growth, but it does not eliminate the risk entirely, which is why temperature control works alongside oxygen management rather than replacing it.
Laboratory culture
In clinical and research labs, culturing anaerobes requires strict oxygen-free conditions during handling and transport. The Merck Manual is direct about this: samples suspected of containing obligate anaerobes need to reach the lab quickly and in transport containers filled with oxygen-free gas mixtures like nitrogen, carbon dioxide, and hydrogen. Exposing a sample to air even briefly can kill off the very organisms you are trying to culture. For aerotolerant organisms, the handling requirements are less extreme, but for microaerophiles, you need a specialized environment with 2 to 10 percent oxygen, often achieved with a candle jar or controlled gas mixture. Identifying which category your organism belongs to determines your entire culture protocol.
Hygiene and infection
Human body environments are not uniformly oxygenated. The surface of your skin is aerobic, but deep wounds, the gut lumen, gum pockets, and certain tissues can be low-oxygen or anaerobic. Obligate anaerobes thrive in those pockets, which is why deep puncture wounds and poorly debrided tissue can harbor dangerous organisms. Facultative anaerobes are particularly adaptable pathogens because they can colonize both surface tissues and deeper, less oxygenated compartments without skipping a beat. This adaptability is part of what makes organisms like E. coli effective as opportunistic pathogens in the wrong location.
For everyday hygiene practice, the takeaway is that removing dead tissue, keeping wounds clean and exposed to air, and not creating sealed anaerobic pockets (like leaving a bandage on too long without cleaning) all reduce the conditions that favor anaerobic pathogen growth. Oxygen requirement classification is, at its core, a prediction tool: it tells you which environments will favor which organisms, so you can make smarter decisions about preventing growth where you do not want it.
If you want to go deeper on the adjacent categories, articles on strictly aerobic organisms (bacteria that require oxygen to grow) and obligate anaerobes (microorganisms that grow best in the absence of oxygen) round out the full picture and are worth reading alongside this one. Together, the five categories form a complete map of how oxygen shapes the microbial world.
FAQ
If an organism grows in both aerobic and anaerobic conditions, is it always a facultative anaerobe?
No. Aerotolerant anaerobes can also grow regardless of oxygen, but they do not use oxygen for respiration. A quick way to separate them is whether it switches metabolism when oxygen is present, and in many teaching labs the catalase test helps (facultative anaerobes are often catalase positive, aerotolerant often negative).
What if a question says “oxygen is present but it doesn’t use it” and also says it can grow?
That wording most strongly points to an aerotolerant anaerobe. The key is that “doesn’t use it” rules out facultative anaerobes, which can use oxygen for respiration when available, even if they also survive without it.
How can I distinguish aerotolerant anaerobes from obligate anaerobes if both relate to oxygen differently?
Obligate anaerobes cannot survive exposure to oxygen, so they will show no growth or poor survival when oxygen is present. Aerotolerant anaerobes tolerate oxygen exposure and still grow, even though they ferment exclusively and do not use oxygen for respiration.
In thioglycollate broth, what growth pattern would you expect from a facultative anaerobe compared with an aerotolerant anaerobe?
Facultative anaerobes often grow more strongly higher up where oxygen is higher, because they can use oxygen for more efficient energy production. Aerotolerant anaerobes tend to show a more uniform growth pattern because their fermentation-based strategy does not change with oxygen levels.
Why does a catalase test sometimes seem “inconsistent” with oxygen categories?
Because it is an assistive clue, not a perfect definition. Some strains have borderline or variable catalase activity depending on culture conditions, growth phase, and methods. Use it together with oxygen-use wording from the question (or with metabolic tests), not as the only evidence.
Can a facultative anaerobe still grow if oxygen is only present in small amounts?
Yes. Facultative anaerobes do not require high oxygen, they can use whatever oxygen is available and then switch when it drops. In borderline conditions you may see less vigorous growth than in fully aerobic culture, because the organism spends more time in fermentation or anaerobic respiration.
What does “microaerophile” usually imply for growth when oxygen is at normal air levels?
Microaerophiles typically grow best at reduced oxygen (often 2 to 10 percent) and can be inhibited or damaged at atmospheric oxygen. So if the prompt emphasizes reduced oxygen requirements, it is not the same as “grows with or without oxygen.”
Are there any common exam wording traps beyond “uses” versus “tolerates”?
Yes. Verbs like “requires,” “cannot survive,” and “harmed by” usually indicate obligate groups, while “survives,” “tolerates,” and “does not use for respiration” point to aerotolerant. Also watch for phrases like “prefers oxygen” which suggests facultative behavior because it gains an energy advantage when oxygen is present.
In food safety contexts, should I think about oxygen exposure as always “good” for reducing risk?
Not universally. While exposing many anaerobes to air can reduce their risk, some pathogens that are facultative anaerobes can still contaminate surfaces and grow after packaging. The safe takeaway is to combine oxygen management with temperature control and proper handling, because oxygen alone does not eliminate growth risk for facultative organisms.
In clinical culturing, is “less strict oxygen control” always better once you suspect an anaerobe?
No. The level of oxygen control depends on the oxygen-requirement category you suspect. Strict anaerobes require oxygen-free handling during transport, aerotolerant organisms are less sensitive to oxygen exposure, and microaerophiles require carefully reduced oxygen rather than oxygen-free conditions.



